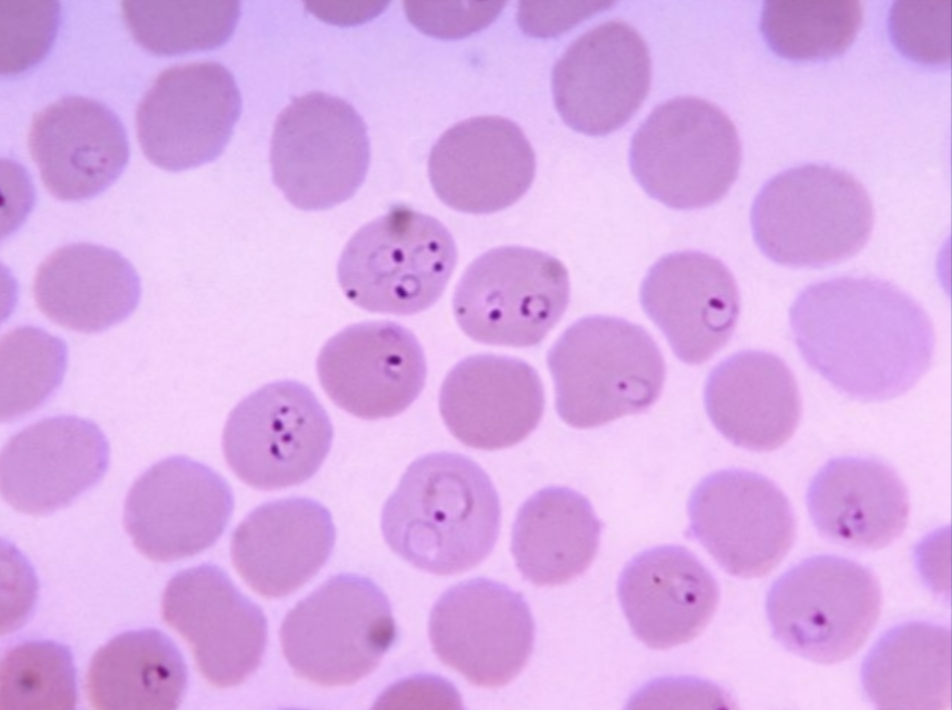
term image

1/32
Looks like no tags are added yet.
Name | Mastery | Learn | Test | Matching | Spaced | Call with Kai |
|---|
No analytics yet
Send a link to your students to track their progress

Euglena
use a organelle called a flagellum to swim
They have chloroplasts to perform photosynthesis.

Paramecium
have cilia that cover their entire surface to help them swim/move

Amoeba (or Ameba)
move using temporary extensions of their cytoplasm called pseudopodia (singular: pseudopodium), often referred to as "false feet".

Leishmania
cause Leishmaniasis
The parasite has a single flagellum in its promastigote stage, which allows it to move
Humans get infected through the bite of an infected sandfly
The sandfly transmits the parasite while feeding on blood.

Vector of Leishmania
Sandfly (size of a fruit fly)

Trypanosoma (in blood smear)
Have flagella
Know how human can be infected
Western Hemisphere, bloodsucking bugs (“kissing bugs”) carry trypanosomes
The bugs defecate while feeding, and infection results when a person rubs infected feces into the bite wound or eye

Trichomonas
Cause Trichomoniasis
Have flagella
Primarily through sexual contact (person-to-person during intercourse)
It is a sexually transmitted infection (STI)

Giardia (cysts)
cysts are shed in the host’s feces
they don’t cause symptoms but are the infective form

Giardia (trophozoite)
Have flagella
Die quickly outside host
Not infective
In host’s small intestine, cause the GI symptoms

Entameba (cyst)
Causes Amoebiasis
Cysts are shed in host’s feces
When a trophozoite, Entameba moves using pseudopods
Cysts are the infective stage, trophozoites cause symptoms
Humans get infected with Entameba by ingesting its cyst form, usually in fecally-contaminated food or water
Can ulcerate the intestinal lining, cause abscesses

Balantidum (trophozoite)
Causes Balantidiasis or Balantidiosis
Common in the host’s small intestine
Trophozoites cause the symptoms of balantiasis
Trophozoites have cilia
They don’t live long outside the host, not infective
Plasmodium (ring stage)
on a blood smear
Causes malaria
Female mosquitoes, as they feed on blood, transmit this from person to person

Fasciola hepatica egg
Commonly found in water
Expelled in the feces of the infective definitive host

Life cycle of Faciola hepatica

Fasciola hepatica miracidium larva fluke
What hatches out of the eggs
Found swimming in water until die ( 8 hours) or encounter appropriate host snail
Stained red, blue-green, or purple
Bullet shape, same width as microscope pointer on 10x
has cilia

Fasciola hepatica redia larva
Found in the body of appropriate host snail (IH)
Developing cercariae (red objects) inside the redia

Fasciola hepatica cercaria larva
Found swimming in water, after leaving the snail
Does not last very long
swim

Fasciola hepatica metacercaria larva
During this stage these worms are found on aquatic plants
Will remain in this stage until they die or a suitable DH eats the plants

Fasciola hepatica adult (stained)
Hemaphroditic
Found in the liver and bile ducts of DH
Lay numerous eggs and are shed in the host’s feces

Fasciola hepatica adult (unstained)
Hemaphroditic
Found in the liver and bile ducts of DH
Lay numerous eggs and are shed in the host’s feces

Schistosoma adults (male and female)
Found coupled like this when in the intestinal blood vessel, liver tissue, intestinal wall of DH
Male is the shorter thicker part
Female is the longer leaner part
240 million people worldwide are infected with various species of schistosomes

Adult Tapeworm Anatomy

Taenia Eggs (Tapeworm)
Shed in the feces of the DH
Sometimes encased in proglottids

Taenia pisiformis cysticercus
Tapeworm cysticercus larva
Larval stage found in muscle and/or viscera of worm IH
Hooks are hard to see, but are visible in the photo

Taenia pisiformis
Thousands of tiny brown eggs are visible inside the low power views of a mature proglottid

Taenia pisiformis mature (upper) and gravid (lower)
(proglottids)
The presence of fertilized eggs are in the gravid proglottids
Mature proglottids contain the sex organs
Gravid proglottids are shed in DH feces

Echinococcus life cycle

Echinococcus granulosus adult
Has scolex’s sucking discs
The hooks are visible on the very top of the scolex
Canids are the usual definitive hosts; deer and other grazing animals are the usual intermediate hosts
Humans occasionally ingest Echinococcus eggs, becoming accidental intermediate hosts
life-threatening disease (hydatid disease, or cysticercosis) may result due to tissue damage by the developing larvae

Cysticercosis
MRI shows numerous tapeworm larvae (dark, hole-like objects) in a human brain

Enterobius (pinworm)
Adults live in the human colon, emerging at night onto the perianal skin to mate and lay eggs
Humans become infected by ingesting these eggs, and that symptoms are mostly confined to perianal itching and discomfort

Necator (hookworm)
historically common in American South
Adults live attached by their mouthparts to the human intestinal wall
A heavy hookworm infestation can cause anemia

Enterobius v. Necator
(it’s about the mouthparts!)
Enterobius’s mouth is small and pipette-lie
Necator’s mouth has sharp, toothlike “cutting plates”.

Trichinella spiralis (4 or 5 encysted worms visible here)
This is a slice of tongue (or other skeletal muscle) from an infected pig
larval stage
Trichinosis is very rare in the U.S. today, but humans can become infected by consuming undercooked pork or sometimes bear meat